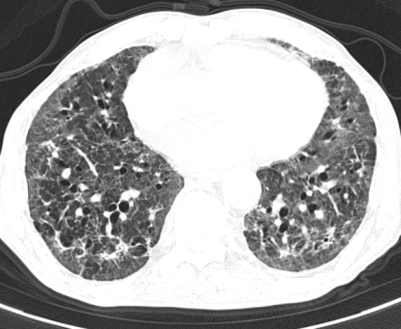

与“罕见肺炎”的41天博弈,青岛市第八人民医院本部院区呼吸与危重症医学科成功救治非HIV感染PJP重症肺炎患者
大众新闻·半岛新闻 2026-01-16 15:56:21原创
半岛网记者 纪豪杰
近日,青岛市第八人民医院本部院区呼吸与危重症医学科团队通过精准诊断与个体化治疗,成功救治一例罕见、危重的非HIV耶氏肺孢子菌肺炎(PJP)合并巨细胞病毒(CMV)、肺栓塞等多重并发症患者。经过41天精心治疗与护理,77岁的王大爷从卧床不起、依赖高流量吸氧,到能自主行走、生活自理,闯过了一道道生命难关。
突发危重病情,罕见病原体暗藏杀机
患者王大爷因“咳嗽、胸闷3天,呼吸困难加重5小时”被120紧急送入本部院区就诊。入院时患者高热、呼吸极度困难,肺部听诊可闻广泛Velcro啰音,血气分析提示Ⅰ型呼吸衰竭,胸部CT显示双肺弥漫性结节斑片影。患者有溃疡性结肠炎病史,曾使用激素治疗,初步诊断为重症肺炎。病情危急,医疗团队立即予以高流量氧疗、抗感染及激素治疗,并由贾兆广副主任医师行床旁气管镜检查,送检支气管灌洗液进行tNGS病原学检测。




胸部CT:双肺弥漫结节斑片影
然而,病情的凶险程度远超预期,检查结果提示D-二聚体显著升高,CTPA提示右下肺动脉肺栓塞,肺部感染亦较前明显进展,病情进一步恶化。在呼吸与危重症医学科主任李芳芳带领下,团队迅速调整方案,加强抗凝与抗炎治疗。



胸部CT及CTPA
关键的tNGS检测结果揭晓了幕后真凶,耶氏肺孢子菌、巨细胞病毒、EB病毒及黑曲霉混合感染。至此,诊断完全明确,这是一例极为罕见的、在非HIV患者身上发生的PJP合并多种病原体感染,并叠加肺栓塞和呼吸衰竭的极危重病例。
精准治疗,应对多重挑战
科室立即启动精准治疗,给予复方新诺明抗肺孢子菌、更昔洛韦抗病毒、伏立康唑抗真菌治疗,甲泼尼龙琥珀酸钠抗炎,兼顾抗凝、高流量氧疗呼吸支持、纠正电解质紊乱等治疗。
在接下来的救治过程中,挑战接踵而至。患者相继出现了血痰、血便、顽固性的低钠血症和心脏早搏等问题,治疗团队如同闯关一般,对每一个新情况都及时研判并调整用药策略。随着治疗的深入,患者的体温首先恢复正常,成为病情好转的曙光。之后的复查CT显示,肺部炎症开始逐步吸收。虽然过程中出现了肺纤维化的迹象,但通过加用抗纤维化药物尼达尼布,这一进程也得到了有效干预。




在呼吸与危重症医学科全体医护人员日以继夜的精心照护下,患者的康复之路渐渐清晰。他从完全依赖高流量吸氧,到可以尝试在床旁活动;从需要全程卧床,到能够借助鼻导管吸氧下床如厕。最终,在入院41天后,王大爷成功脱氧,能够自主缓慢行走,基本恢复了生活自理能力,顺利出院。

此例极高难度患者的成功救治,充分彰显了八医呼吸与危重症医学科在疑难复杂重症领域的综合诊治实力与高水平团队协作能力。从快速的病因诊断,到应对治疗中层出不穷的并发症,每一步都体现了现代医学的精准与人文关怀的温暖,为类似危重患者的救治积累了宝贵经验。
责任编辑:孙贴静
